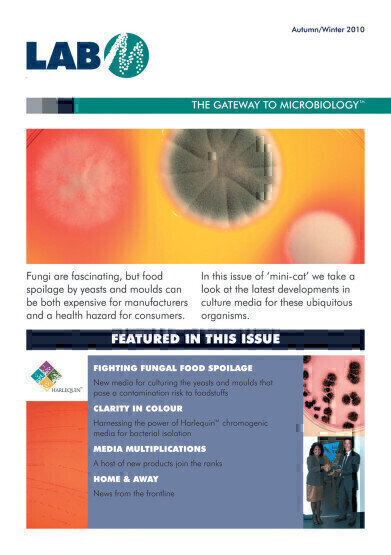
Hot off the Press

Laboratory products
Hot off the Press
Apr 05 2011
The new issue of Lab M’s minicatalogue is now available free of charge. Packed with features, news and the latest microbiology product information, this 8-page issue is available by simply mailing info@labm.com.
Subscribers can tell Lab M if they’d like the print edition or prefer to receive it electronically.
Fascinating fungi - or more correctly, how to culture yeasts and moulds in the fight against food spoilage – is one of the main topics. Readers can also learn about a decade of development for Lab M’s Harlequin™ chromogenic media, and in particular about the ISO formulations and their applications for the food industry; a new addition to the MacConkey agar family; a Staphylococcus aureus enrichment broth; and a new anaerobe medium for culturing Clostridia.
Digital Edition
Lab Asia Dec 2025
December 2025
Chromatography Articles- Cutting-edge sample preparation tools help laboratories to stay ahead of the curveMass Spectrometry & Spectroscopy Articles- Unlocking the complexity of metabolomics: Pushi...
View all digital editions
Events
Jan 21 2026 Tokyo, Japan
Jan 28 2026 Tokyo, Japan
Jan 29 2026 New Delhi, India
Feb 07 2026 Boston, MA, USA
Asia Pharma Expo/Asia Lab Expo
Feb 12 2026 Dhaka, Bangladesh